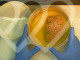

El nuevo director adjunto operativo de la Policía Nacional se curtió en las calles. En Eivissa persiguió y doblegó a bandas especializadas en robar relojes a turistas ricos. También ha coordinado dispositivos como el que veló por la seguridad del juicio del caso Nóos, con la Infanta Cristina en el banquillo
Interior nombra DAO de la Policía al jefe superior de Illes Balears tras el cese del anterior por una denuncia de violación
Durante los veranos de Eivissa, cuando la fiesta deja de distinguir entre noche y día y los yates llenan el puerto deportivo, una parte de la delincuencia europea también aterriza en la isla. Bandas itinerantes que viajan siguiendo el calendario del ocio nocturno -la Costa Azul, Mónaco, Saint-Tropez...- observan durante horas a turistas adinerados y esperan el momento preciso para actuar: un tirón de reloj a la salida de una discoteca, un asalto rápido en la terraza de un restaurante de lujo, un coche preparado para abandonar la isla antes de que amanezca. Perseguir a esos grupos fue durante años parte del trabajo cotidiano de la Policía Nacional en la isla. Y el mando que coordinaba esos operativos era el comisario José Luis Santafé, a quien el Ministerio del Interior ha recurrido para sustituir a José Ángel González, denunciado por agresión sexual por parte de una subordinada, como nuevo director adjunto operativo (DAO) de la Policía Nacional.
Alejado de las grandes unidades centrales y curtido en las calles, Santafé Arnedo (Madrid, 1965) nació y creció en el barrio de Malasaña, un escenario donde, en los años ochenta, la droga y la conflictividad formaban parte del paisaje cotidiano. De ese contexto emergió una vocación temprana que le situaría en la escuela clásica de la seguridad ciudadana y a una generación de mandos que accedieron al cuerpo por la vía académica. En 1990 ingresó en la escala ejecutiva de la Policía Nacional y comenzó su carrera en la División de Formación y Perfeccionamiento. Muy pronto dio el salto al terreno operativo. En 2005 ascendió a inspector jefe, en 2012 a comisario y en 2020 alcanzó el rango de comisario principal, la categoría más alta dentro del escalafón policial.
Su carrera se ha desarrollado sobre todo en destinos territoriales. Desde los años noventa ha alternado puestos en Madrid, Canarias y Balears. Fue en este último archipiélago, marcado por la presión turística, la delincuencia vinculada al ocio nocturno y la necesidad de coordinar grandes dispositivos de seguridad durante la temporada alta, donde empezó a especializarse en seguridad ciudadana y policía judicial. Antes de ser nombrado jefe superior, dirigió la Comisaría de Eivissa, uno de los territorios más exigentes y complejos para la Policía Nacional, atravesado por la presencia de hordas de turistas cada verano y la delincuencia itinerante.
Durante esta etapa, Santafé coordinó varios operativos contra grupos criminales que se desplazaban a la mayor de las Pitiüses para robar a turistas de alto poder adquisitivo. Uno de los más conocidos fue la desarticulación de la llamada 'banda del Rolex', dedicada a asaltar a visitantes a la salida de discotecas y restaurantes de lujo. En el verano de 2014, las investigaciones permitieron detener a varios miembros de grupos itinerantes -algunos procedentes de Italia y del norte de África- y recuperar relojes valorados en cientos de miles de euros. Ese tipo de delincuencia era habitual en la Ibiza de los grandes clubs y los yates: robos rápidos, víctimas con objetos de lujo y delincuentes que intentaban abandonar la isla antes de ser identificados. La operación se convirtió en uno de los golpes policiales más visibles de aquella etapa.
Otro de los frentes abiertos durante su paso por Eivissa fueron las bandas especializadas en robos con butrón, perpetrados por grupos que entraban en tiendas y joyerías perforando paredes desde locales contiguos. Bajo el mando de Santafé, la Policía Nacional desarticuló dos grupos organizados que operaban en la isla y que actuaban de forma muy planificada: estudiaban los locales durante semanas, alquilaban pisos o almacenes cercanos y ejecutaban el golpe de madrugada. Las investigaciones culminaron con varias detenciones y con la recuperación de parte del material robado. En un territorio con una economía muy dependiente del turismo y del comercio de lujo, esos golpes tenían un considerable impacto mediático y económico.
Un oscuro magnate y una infanta en el banquillo
Desde Eivissa, Santafé recaló en 2016 en la Jefatura de la Brigada Provincial de Seguridad Ciudadana en Palma. Desde ahí participó en la coordinación de uno de los dispositivos de seguridad más sensibles que se han desplegado en las islas, el del juicio del caso Nóos, que por primera vez sentó en el banquillo a un miembro de la familia real, la infanta Cristina, cuya presencia acaparó una enorme atención internacional y requirió el despliegue de un amplio dispositivo policial: había que garantizar la seguridad en torno a las dependencias donde durante seis meses se celebró la vista oral, controlar el acceso de los medios de comunicación y coordinar la llegada de los principales acusados.
Su nombre también quedó asociado a otra de las grandes causas judiciales instruidas en las islas, el caso Cursach, cuyas investigaciones situaron al magnate Bartolomé Cursach en el epicentro de una trama político-policial dirigida a perpetuar su autoridad en la noche. Durante meses, la instrucción avanzó entre detenciones, registros y un goteo constante de policías locales imputados y encarcelados de forma preventiva en el marco de unas pesquisas que llegó a sacudir a buena parte de la Policía Local de Palma.
En aquel contexto, Santafé mantuvo una posición muy crítica con la actuación del juez instructor del caso, Manuel Penalva, y del fiscal, Miguel Ángel Subirán, a quienes reprochó haberse excedido en la conducción de la instrucción. Años después, la causa acabaría dinamitada y Cursach, absuelto por falta de pruebas. Por su parte, Penalva y Subirán acabarían condenados a nueve años de prisión por delitos de obstrucción a la Justicia, coacciones y omisión del deber de perseguir filtraciones mientras la causa se encontraba bajo secreto sumarial.
Cuando en 2022 fue nombrado jefe superior de Policía en Balears, Santafé pasó a dirigir todo el dispositivo policial del archipiélago, con cerca de 1.700 agentes repartidos entre Mallorca, Eivissa, Menorca y Formentera. El principal desafío era la estacionalidad extrema: cada verano, la población efectiva de las islas se multiplica y, con ella, los retos en materia de seguridad: la delincuencia vinculada al turismo y al ocio nocturno, las redes de narcotráfico marítimo y los grandes dispositivos para eventos y temporada alta. También la presión migratoria en las costas, cuyo incremento, en palabras de Santafé, se ha convertido en uno de los retos crecientes para la policía en las islas. Gestionar ese escenario implica desplegar cada temporada macrooperativos de refuerzo policial, coordinación con Guardia Civil y Policía Local y dispositivos específicos en aeropuertos, puertos y zonas de ocio.
Al término de 2025, en un encuentro con los periodistas para dar cuenta del año, Santafé advirtió de los cambios producidos en la delincuencia ligados al aumento de población y al récord de visitantes en Balears, y manifestó que algunos delincuentes “han vuelto al pasado” con prácticas como los robos en el interior de vehículos, un delito que “prácticamente había desaparecido” en las islas. En muchos casos, añadió, ni siquiera logran llevarse nada porque los coches no contienen objetos de valor, pero, aun así, obligan a la policía a redoblar esfuerzos para combatirlos.
Con más de tres décadas de carrera a sus espaldas, Santafé aterriza ahora en el corazón operativo de la Policía Nacional, desde el que se encargará de coordinar las principales comisarías generales así como supervisar las operaciones y la planificación estratégica del cuerpo. Interior ha optado por un perfil técnico y relativamente ajeno a las luchas internas que históricamente han marcado la cúpula policial. El reto que tiene por delante no es menor: recomponer la moral del cuerpo tras el escándalo que provocó la caída de su antecesor y devolver estabilidad a una de las instituciones clave del sistema de seguridad del Estado.

El operativo, en el que participa un helicóptero, se efectúa durante una jornada marcada por las lluvias en Catalunya
Los Bomberos de la Generalitat buscan desde primera hora de la tarde de este viernes al conductor de una furgoneta que ha sido arrastrada por el agua en la riera Giola a su paso por Llinars del Vallès (Barcelona).
El vehículo se ha encontrado en la desembocadura de la riera con el río Mogent, que transcurre paralelo a la autopista AP-7, según informa la Agència Catalana de Notícies (ACN).
Los Bomberos han destinado diecisiete dotaciones en la zona, con efectivos submarinistas y el apoyo de un helicóptero. Los servicios de emergencias han podido acceder al vehículo y han constatado que estaba vacío para iniciar la búsqueda del conductor. Los Mossos d'Esquadra y la Policía Local de Llinars participan en la operación.
Sin llegar a los niveles de los últimos temporales que han afectado la comunidad, la borrasca Regina ha dejado este viernes precipitaciones moderadas en buena parte de Catalunya, que han sido que localmente fuertes, persistentes, y con tormenta en el prelitoral, como la comarca del Vallès Oriental, donde está la riera en la que ha desaparecido el conductor de la furgoneta.

Los especialistas examinaron capas diminutas conservadas bajo el poblado de Molino Casarotto mediante métodos como micro-FTIR y rayos X, lo que permitió detectar partículas alteradas por calor y residuos de actividades repetidas
El pequeño pueblo que alberga un castillo de origen musulmán y una cueva famosa por sus pinturas rupestres y sus murciélagos
Ningún grupo humano puede habitar un lugar durante mucho tiempo si no dedica parte del día a tareas básicas que mantienen el espacio en condiciones de uso. Las actividades de mantenimiento han acompañado siempre la vida diaria, porque cualquier comunidad necesita limpiar, retirar restos o ordenar el lugar donde vive.
Incluso los pueblos muy antiguos tenían que afrontar esas labores de forma regular si querían seguir usando sus viviendas. Sin ese trabajo cotidiano el interior de las casas se llenaría de cenizas, restos orgánicos o suelo deteriorado por el paso continuo de personas. Cada sociedad desarrolló soluciones para gestionar esos problemas prácticos. Ese mismo tipo de tareas constituye el punto de partida para entender cómo funcionaban muchos asentamientos prehistóricos.
El equipo científico desentrañó lo que ocurría bajo las cabañas gracias a pruebas microscópicas muy detalladas
Un estudio publicado en Archaeological and Anthropological Sciences reconstruye con gran precisión cómo funcionaban esas tareas en el asentamiento neolítico de Molino Casarotto, en el norte de Italia. El equipo de investigación analizó sedimentos conservados bajo las viviendas mediante técnicas microscópicas de alta resolución. Esos fragmentos de suelo guardaban cenizas, restos orgánicos y partículas alteradas por el fuego. El examen detallado de esas capas permitió identificar actividades repetidas dentro y alrededor de las casas.

El yacimiento de Molino Casarotto conserva depósitos que proceden directamente de la vida diaria. Allí los investigadores aplicaron análisis micromorfológicos junto con técnicas como micro-FTIR y difracción de rayos X para estudiar el sedimento sin destruirlo. Con ese método observaron capas diminutas que registran acciones humanas repetidas.
Algunas zonas acumulaban restos procedentes de hogares y placas de cocción renovadas varias veces. También aparecieron piedras calentadas que se usaron durante la preparación de alimentos. Gracias a ese registro microscópico fue posible reconstruir la forma en que se utilizaban los espacios domésticos.
Las viviendas mostraban señales claras de cuidado continuo y reformas periódicas del terreno
Otra parte del estudio se centró en cómo se mantenía el interior de las viviendas. Las capas del suelo muestran superficies barridas de forma reiterada y renovaciones periódicas del terreno. En varias zonas aparecieron sedimentos compactados por el paso frecuente de personas. También se detectaron capas finas añadidas para nivelar el suelo y mejorar la habitabilidad del interior.
Ese tipo de reparación del suelo permitía mantener una superficie más cómoda para caminar y trabajar dentro de la vivienda. La ausencia de acumulaciones desordenadas de restos indica, por lo tanto, que los habitantes retiraban los desechos con frecuencia.
Durante mucho tiempo la arqueología prestó mayor atención a transformaciones amplias como la domesticación de plantas, la expansión agrícola o la construcción de grandes monumentos. Sin embargo, varios estudios recientes han empezado a examinar el día a día de las comunidades prehistóricas.
Analizar la vida cotidiana permite entender cómo se organizaban las casas, cómo se distribuían los espacios y qué rutinas se hacían en la vida diaria. Esa perspectiva muestra que la experiencia en el hogar tenía un papel decisivo en las primeras comunidades agrícolas. Las actividades del hogar también formaban parte de la estructura social de esos grupos.
Los fuegos encendidos dentro de las cabañas revelaban una cocina estable y repetida
Las huellas más claras de cocina aparecieron en zonas de combustión localizadas dentro de las viviendas. Allí los investigadores identificaron capas de ceniza fina, restos carbonizados y sedimentos alterados por calor. Estos indicios indican que el fuego se encendía con frecuencia en lugares definidos del interior.

Los residuos asociados muestran que el fuego se utilizaba para preparar alimentos y para otras tareas domésticas. En algunos casos aparecieron conchas descartadas que habían sido calentadas a menos de 200°C, lo que sugiere que se hervían o se asaban lentamente con ayuda de piedras calientes. Esa repetición de encendidos demuestra que las casas funcionaban como espacios de cocina estables.
Los vecinos apartaban la basura a zonas concretas y creaban montones separados
Fuera de las áreas habitadas se localizaron depósitos de desecho. Allí se acumulaban cenizas, fragmentos de materiales y restos orgánicos retirados del interior de las casas. La posición de esos depósitos indica que los habitantes trasladaban los residuos a lugares concretos del asentamiento.
Con el paso del tiempo se formaron montones de desecho diferenciados del espacio donde se vivía, como si fueran vertederos. Esa separación muestra una organización clara del asentamiento y un sistema regular para retirar lo que se producía dentro de las viviendas.

Mantiene el nivel de los 17.000 puntos, a pesar de la escalada de los precios del petróleo y el gas, disparados tras el ataque a Irán y la amenaza de Catar sobre un cese de las exportaciones
El Ibex cae un un 2,62% tras el ataque a Irán, su mayor descenso desde abril
El Ibex 35, el índice de referencia de la bolsa española, ha cerrado la semana con una caída acumulada del 7% en cinco jornadas. Es su mayor paso atrás desde la invasión de Ucrania, cuando el desplome en una semana alcanzó el 9%.
Lo hace, además, después de que el petróleo se haya disparado casi un 26% tras el ataque ilegal de Estados Unidos e Israel a Irán. También, arrastrada por las dudas sobre qué pasará con el gas en las próximas semanas, tras la advertencia de Catar, que puede cerrar el grifo de las exportaciones.
En el siguiente gráfico se ve la evolución del Ibex desde comienzo del año.
En concreto, el Ibex ha concluido la sesión del viernes con un retroceso de 170,8 puntos hasta cerrar en los 17.074,4 enteros. Lejos quedan las cotas que alcanzaba hace solo siete días, cuando los resultados de las mayores empresas cotizadas en bolsa lo impulsaron por encima de los 18.360 puntos y encadenó varias semanas con máximos históricos. Una bonanza que, tras el ataque a Irán, se ha difuminado por completo. De hecho, si se ve la cotización en lo que va de año, el selectivo acumula una caída del 1,35%.
En el siguiente gráfico se ve la cotización empresa por empresa, de las 35 compañías que integran el Ibex.
Este viernes, el precio del crudo Brent, el de referencia para Europa, ha llegado a cotizar en casi 92 dólares, el precio más alto desde abril de 2024, con una subida de más del 7% respecto al jueves. En total, en una semana, el barril se ha disparado cerca de un 26% tras la volatilidad provocada por la incertidumbre en Oriente Medio.
Mientras, el petróleo West Texas Intermediate (WTI), de referencia para Estados Unidos, subía más de un 10% al inicio de la sesión hasta cotizar en los 89,61 dólares, su mayor precio desde octubre de 2023, con una revalorización acumulada en la semana de casi el 30%, según recoge Europa Press.
Y en el siguiente gráfico se desglosa la evolución del crudo en las últimas semanas, el de referencia en Europa.
Este viernes, el ministro de Energía de Catar, Saad al-Kaabi, ha advertido de que el barril de crudo podría alcanzar los 150 dólares si el conflicto continúa y que los países exportadores de gas y petróleo del golfo Pérsico pueden tener que suspender su producción en cuestión de semanas, tras los ataques a instalaciones y el cierre del estrecho de Ormuz.

Victòria Roselló afirmó en la comisión de investigación del Congreso que días antes del 29 de octubre de 2024 ya "se veía que iba a ser un día muy peligroso”
Hemeroteca - La jefa de meteorología de À Punt, en el Congreso: “Es incontestable que en la dana hubo información suficiente”
La jueza de la dana ha citado, en condición de testigo, el próximo 15 de abril a Victòria Roselló, la jefa de Meteorología de À Punt, la televisión autonómica que el 29 de octubre de 2024, trágica jornada que acabó con 230 fallecidos, emitió en directo durante todo el día el peligro sobre el terreno. Los meteorólogos de la cadena pública alertaron reiteradamente, tanto en los informativos como en la programación a lo largo de aquella mañana del inminente peligro de la dana.
La meteoróloga fue citada hace casi un año, aunque una diligencia de ordenación de la Letrada de la Administración de Justicia ha puesto fecha en la agenda de testificales del procedimiento.
Roselló compareció el pasado 23 de febrero en la comisión de investigación del Congreso y afirmó que antes del 29 de octubre de 2024 ya se tenía suficiente información para poder anticipar que se avecinaba “un temporal histórico”.
La profesional manifestó que “fue una situación que se vio muchos días antes, en meteorología, cuando se ve con tantos días de antelación, es una situación que hay que seguir porque puede haber modificaciones, pero en este caso, se siguió muy bien desde el principio y no mostró muchas variaciones; a medida que se acercaba el martes 29 de octubre, se veía que iba a ser un día muy peligroso”.

Situado en lo alto de un cerro, el castillo de Culla revela su papel decisivo en la organización templaria y el desarrollo urbano medieval del municipio
La capital del noroeste de España que puedes recorrer cómodamente a pie y que es una de las ciudades Patrimonio de la Humanidad menos conocidas
En el interior de la provincia de Castellón, dentro de la comarca del Alto Maestrazgo, el municipio de Culla conserva un conjunto urbano que remite directamente a su pasado medieval. El casco antiguo de la localidad fue reconocido como Bien de Interés Cultural en 2004 debido al valor patrimonial de su trazado y de los edificios que se mantienen en pie desde distintas etapas históricas. A esta protección se suma su incorporación a la red de Los Pueblos Más Bonitos de España, una asociación que agrupa municipios con un patrimonio histórico destacado.
El origen del asentamiento y de su sistema defensivo se remonta a la etapa de presencia musulmana en la península ibérica, cuando se levantó una fortificación en la parte más elevada del cerro donde hoy se sitúa el pueblo. Tras la conquista cristiana del territorio, el enclave cambió de manos y pasó a formar parte de los dominios de la Orden del Temple a comienzos del siglo XIV.
Ese episodio marcó de forma decisiva la evolución histórica del municipio: Culla fue el último territorio que adquirieron los templarios antes de la desaparición oficial de la orden en 1312. La presencia de la organización militar dejó una huella que todavía puede identificarse en la estructura urbana del casco antiguo y en los restos del castillo que domina el paisaje desde la zona más alta de la población.
Durante siglos, la fortaleza desempeñó una función estratégica dentro del sistema defensivo del interior castellonense. Con el paso del tiempo y tras distintos episodios históricos, el recinto quedó en ruinas. En la actualidad, un proyecto de rehabilitación impulsado por el Ayuntamiento busca recuperar parte de ese patrimonio y facilitar su visita, incorporándolo de nuevo al recorrido histórico del municipio.
El castillo templario que dominaba el territorio
En la parte más elevada de Culla, a unos 1.121 metros de altitud, se encuentran los restos de la antigua fortaleza que durante siglos controló el territorio del Alto Maestrazgo. La ubicación permitía observar amplias zonas del entorno y supervisar las rutas que atravesaban esta región del interior de Castellón.
El origen del castillo se sitúa en época islámica, cuando se levantó una primera estructura defensiva. A lo largo de los siglos posteriores el recinto fue ampliado y reforzado, un proceso que continuó hasta aproximadamente el siglo XIV. El conjunto estaba formado por varios recintos defensivos con murallas, torres y dependencias adaptadas a la topografía del cerro. La fortaleza adquirió un papel destacado cuando pasó a manos de la Orden del Temple, un hecho que convierte al castillo de Culla en uno de los últimos territorios templarios antes de la desaparición oficial de la orden.
El deterioro del recinto se produjo principalmente durante el siglo XIX. En el contexto de la primera Guerra Carlista, el castillo fue destruido y gran parte de sus estructuras quedaron reducidas a ruinas. Desde entonces, numerosos restos permanecieron ocultos bajo derrumbes y acumulaciones de tierra.
El proyecto de rehabilitación que se desarrolla en la actualidad pretende recuperar parte de ese patrimonio. Las actuaciones incluyen excavaciones arqueológicas en uno de los sectores del castillo con el objetivo de sacar a la luz estructuras que permanecían cubiertas por los materiales acumulados con el paso del tiempo. Al mismo tiempo, los trabajos contemplan la consolidación de dos elementos clave del conjunto: la Torre del Homenaje y la denominada Torre Menor. Estas intervenciones buscan garantizar la conservación de las estructuras que aún se mantienen en pie y evitar nuevos procesos de deterioro.
La actuación incluye además medidas destinadas a mejorar la experiencia de quienes visiten el recinto. Para ello se prevé adaptar los accesos e instalar pasarelas elevadas que permitan recorrer el espacio sin afectar a los restos arqueológicos. De esta forma, el castillo vuelve a integrarse en el itinerario patrimonial del municipio y permite interpretar su evolución histórica.
Un casco histórico con huellas medievales
El castillo forma parte de un conjunto patrimonial más amplio que se extiende por el casco antiguo de Culla. Durante la Edad Media, la población estuvo protegida por un recinto amurallado que controlaba los accesos al núcleo urbano mediante tres puertas principales. De esas entradas históricas, solo una se mantiene en pie en la actualidad. Se trata de la Porta Nova, reconstruida durante el siglo XIV. Este acceso presenta un arco que permitía el paso de caballos con jinete, una característica habitual en las entradas de las poblaciones fortificadas de la época.
El entramado urbano conserva calles estrechas y viviendas tradicionales que reflejan la evolución histórica del municipio. Entre las vías más representativas se encuentra el carrer del Pla, que durante la Edad Media conectaba la antigua plaza del mercado con el centro del pueblo. A lo largo de esta calle todavía se conservan casas de piedra que mantienen elementos vinculados a la actividad comercial de la época, como anillas metálicas utilizadas para sujetar animales de carga.
Cerca de este eje urbano se encuentra la Casa Abadía y la iglesia parroquial del Salvador, construida a comienzos del siglo XVIII sobre un templo anterior. El edificio forma parte de los espacios religiosos más destacados del municipio. El patrimonio de Culla incluye además varios edificios vinculados a distintas etapas de su historia. Entre ellos se encuentra el inmueble conocido como La Presó, levantado entre los siglos XIII y XIV. Originalmente, funcionó como granero del comendador y siglos después fue utilizado como prisión durante las guerras carlistas.
Fuera del núcleo urbano también se conservan ermitas históricas vinculadas a la tradición religiosa del municipio. Entre ellas destacan la ermita de San Roque, construida en el siglo XVI, y la de San Cristóbal, levantada a finales del siglo XVIII. El conjunto de estos elementos refleja la evolución histórica de una población marcada por su pasado medieval. La recuperación del castillo y la conservación del casco antiguo forman parte de un proceso destinado a preservar ese patrimonio y a facilitar que residentes y visitantes puedan recorrer los espacios que explican la historia de Culla.

Será la primera vez que se ondee una bandera rusa en unos Juegos Paralímpicos desde Sochi 2014, tras la resolución aprobada en la asamblea del Comité Paralímpico Internacional (IPC, por sus siglas en inglés)
¿Por qué es Indian Wells el quinto Grand Slam? Historia y legado del torneo de tenis
Los Juegos Paralímpicos de Invierno 2026 arrancan con un traspié. Doce países han anunciado que no participarán en la ceremonia de apertura de la cita deportiva, que se celebra este viernes en el Arena di Verona, en señal de protesta por la presencia en la competición de Rusia y Bielorrusia con sus símbolos nacionales. Entre ellos, la bandera que portan los deportistas y que también se puede apreciar en la vestimenta. También podrán sonar sus himnos.
Hasta el momento, han confirmado su negativa a desfilar o a participar Canadá, Croacia, República Checa, Estonia, Finlandia, Letonia, Lituania, Polonia, Países Bajos, Ucrania, Alemania y Francia.
La participación de deportistas rusos y bielorrusos con bandera propia será un hito en la competición. Será la primera vez que se ondee una bandera rusa en unos Juegos Paralímpicos desde Sochi 2014, primero por las sanciones por un programa de dopaje patrocinado por el estado y luego por la invasión rusa en Ucrania, de la que se cumplen cuatro años.
El Comité Paralímpico Internacional (IPC, por sus siglas en inglés) se escuda en la resolución aprobada por la mayoría de sus miembros en su última asamblea, celebrada el pasado mes de octubre. En ella, se acordó el levantamiento de la sanción por la que no podían concurrir con sus símbolos nacionales. Un acuerdo que se votó y que salió adelante sin unanimidad.
“De la misma manera que el IPC respeta plenamente la decisión de la Asamblea General del IPC de no mantener las suspensiones parciales de la CPN de Bielorrusia y la CPN de Rusia, también respetamos plenamente las decisiones de cada federación internacional con respecto a los deportes que rigen”, dijo en su momento el presidente del comité, Andrew Parsons. Una posición en la que se reafirma y tacha de democrática.
Uno de los países más críticos ha sido precisamente Ucrania. “Permitir la presencia de símbolos estatales de los agresores en un evento deportivo internacional es inaceptable mientras continúa la guerra a gran escala de Rusia contra Ucrania, apoyada por Bielorrusia”, escribió el Ministerio de Asuntos Exteriores ucraniano en su cuenta de X.
El Comité Paralímpico Español (CPE) votó en contra de levantar esa sanción, pero admite que no puede hacer nada porque se trata de una decisión votada en el seno de la IPC, de acuerdo con fuentes consultadas por EFE. En cualquier caso, no comparten la resolución.
Solo doce países han anunciado que no estarán en la ceremonia de apertura, uno de los momentos más destacados de cualquier cita olímpica: Canadá, Croacia, República Checa, Estonia, Finlandia, Letonia, Lituania, Polonia, Países Bajos, Ucrania, Alemania y Francia.
Banderas e himnos rusos y bielorrusos
Seis deportistas rusos y cuatro bielorrusos participarán en los Juegos Paralímpicos de invierno representando a sus respectivos países bajo su propia bandera. Diez atletas que también podrán escuchar sus himnos, en el caso de que alguno de ellos consiga una medalla de oro en los Juegos Paralímpicos de Invierno 2026 de Milano Cortina.

Los investigadores creen que propiedades como la transparencia o las formas geométricas pudieron despertar la curiosidad de los primeros homínidos
Los chimpancés y bonobos reconocen a sus amigos después de décadas sin verlos
¿Por qué los seres humanos se sienten atraídos por los cristales? Esta curiosa pregunta ha sido el origen de un nuevo estudio liderado por científicos españoles, que sugiere que esa fascinación podría tener raíces mucho más profundas de lo que se pensaba. Especialmente después de que en distintos yacimientos arqueológicos se encontraran cristales recolectados por homínidos hace cientos de miles de años, sin una utilidad aparente. La investigación ha sido dirigida por Juan Manuel García-Ruiz, profesor Ikerbasque en el Donostia International Physics Center (DIPC), y se ha publicado en la revista Frontiers in Psychology.
Ante la imposibilidad de estudiar directamente el comportamiento de los homínidos prehistóricos, el equipo decidió analizar la reacción de chimpancés, nuestros parientes vivos más cercanos desde el punto de vista genético. Los experimentos se realizaron con chimpancés rescatados del tráfico ilegal y acogidos por la Fundación Chimpatía en el Centro de Rescate de Primates Rainfer, en Madrid. Allí viven animales acostumbrados al contacto humano y a interactuar con objetos que no forman parte de su entorno natural.
“Demostramos que los chimpancés endoculturados no sólo se sienten atraídos por los cristales sino que también tienen la capacidad de distinguirlos claramente de otras piedras con características similares”, explica García-Ruiz, autor principal del estudio. Según el investigador, “fue una grata sorpresa descubrir lo fuerte y aparentemente natural que era la atracción de los chimpancés por los cristales, lo que sugiere que la sensibilidad hacia este tipo de objetos puede tener profundas raíces evolutivas”.
Se hicieron varios experimentos durante el estudio
Para comprobarlo, los científicos diseñaron varios experimentos. En el primero colocaron un gran cristal, al que denominaron “el monolito”, junto a una roca común de tamaño parecido. Aunque al principio ambos objetos llamaron la atención de los animales, pronto se inclinaron por el cristal. Los chimpancés lo arrancaron de la plataforma donde estaba colocado y comenzaron a inspeccionarlo, girándolo y observándolo desde distintos ángulos.
Uno de ellos, Yvan, se lo llevó incluso a los dormitorios para examinarlo con más calma. Cuando los cuidadores intentaron recuperarlo, los animales se resistieron a devolverlo y solo aceptaron intercambiarlo por algunos de sus alimentos favoritos, como plátanos y yogur.
En un segundo experimento, los investigadores mezclaron pequeños cristales de cuarzo y calcita con una veintena de guijarros redondeados. Los chimpancés fueron capaces de identificar y escoger los cristales en cuestión de segundos. “Los primeros resultados fueron muy informativos e interesantes, sobre todo en el momento en que Yvan escogió un cristal de cuarzo entre los guijarros para observar detenidamente su transparencia”, señala García-Ruiz.
Después, el equipo añadió cristales con distintas propiedades (cuarzo, calcita y pirita) pero con una característica común: su forma poliédrica. Los chimpancés siguieron siendo capaces de separarlos del resto de piedras. En uno de los casos, la chimpancé Sandy llegó a clasificar las piezas en dos grupos: por un lado los guijarros redondeados y por otro los cristales con superficies planas.
Los investigadores creen que propiedades como la transparencia o las formas geométricas pudieron despertar la curiosidad de los primeros homínidos. En la naturaleza predominan las formas curvas de árboles, montañas, nubes o ríos, mientras que los cristales presentan superficies planas y ángulos definidos, algo mucho menos habitual en el entorno natural.
El estudio abre una nueva vía para explicar la fascinación que siente el ser humano por los cristales y contribuye a la comprensión de las raíces evolutivas. Su rareza, su atractivo óptico y su singularidad geométrica podrían haberles conferido un significado especial, funcionando como “representaciones físicas de ideas que trascienden el mundo inmediato y tangible” que ellos no conseguían comprender. “Ahora sabemos que los cristales han estado en nuestras mentes durante al menos seis millones de años”, concluye García-Ruiz.